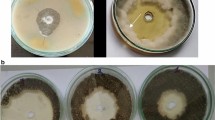

Abstract
Rust, caused by Phakopsora pachyrhizi, is an important disease affecting soybean production. Induced resistance, using an array of abiotic or biotic inducers of resistance, becomes a very promising alternative to minimize fungicide applications for rust control. This study investigated the potential of using Mantus® [copper (20%) and polyphenolic (10%)] to reduce rust symptoms by boosting defense reactions. A 2 × 2 factorial experiment was arranged in a completely randomized design with four replications per sampling time. The factors studied were plants sprayed with water (control) or Mantus® (referred to as induced resistance (IR) stimulus hereafter) that were non-inoculated or inoculated with P. pachyrhizi. Urediniospores germination was reduced by 97% by the IR stimulus in vitro. Meanwhile, rust severity and area under disease progress curve significantly decreased by 68 and 35%, respectively, for IR stimulus-sprayed plants compared to control. Defense-related genes (PAL1.1, PAL1.3, PAL3.1, CHIA1, CHI1B1, LOX, PR10, ICS1, and JAR1) were up-regulated for IR stimulus-sprayed plants compared to control plants during fungal infection. Diseased and IR stimulus-sprayed plants showed less impairment in their photosynthesis (moderate changes on both gas and chlorophyll a fluorescence parameters, linked to great concentrations of chlorophyll a + b and carotenoid) and a more robust antioxidative metabolism (lower concentrations of hydrogen peroxide and anion superoxide, higher superoxide dismutase activity, and lower ascorbate peroxidase, catalase, peroxidase, and glutathione reductase activities) in contrast to control plants infected by P. pachyrhizi. These results highlight the potential of using this IR stimulus for rust management considering its fungistatic effect to reduce urediniospores germination linked to increased resistance of soybean plants to cope with P. pachyrhizi infection more efficiently.
Similar content being viewed by others
Avoid common mistakes on your manuscript.
Introduction
Soybean (Glycine max (L.) Merril) ranks as one of the most economically important oilseeds and biodiesel crops. The legume is the main provider of protein and oil for human consumption, animal feed, and biofuel production (Hartman et al. 2011). However, the occurrence of rust, caused by the biotrophic fungus Phakopsora pachyrhizi H. Sydow & P. Sydow, has contributed significantly to reducing yield due to photosynthetic impairment, profound foliar chlorosis and defoliation, and earlier senescence of diseased plants (Langenbach et al. 2016; Rios et al. 2018).
The lack of soybean varieties exhibiting race-specific resistance against P. pachyrhizi infection places the use of fungicides associated with some cultural practices (e.g., early-maturing cultivars, early sowing dates, detection of the early development of rust symptoms and fungal signs, and a period without growing soybean in the off-season to avoid early urediniospores production) as the control strategies available for farmers to manage rust epidemics and minimize yield losses (Langenbach et al. 2016). Soybean rust control strategies, which contribute to more sustainable agriculture and help farmers depend less on fungicides, deserve to be investigated. Inducers of plant resistance may fit well as an eco-friendly alternative for rust management. It is important to fill out these knowledge gaps to understand better how resistance inducers may modulate plant performance at physiological, biochemical, and molecular levels in coping with pathogen infection. This approach will place the new and yet-to-be-discovered resistance inducers closer to the market and be recognized by the farmers as a sustainable option for crop protection.
Induced resistance (IR) has called the attention of many researchers worldwide. In this regard, plants from cultivars with good agronomic traits, but susceptible to diseases, after being exposed to abiotic or biotic IR stimuli are more prone to activating defense reactions (Siah et al. 2018). During IR, which can be categorized as induced systemic resistance (ISR) or systemic acquired resistance (SAR), plants rely on the signaling pathways mediated by hormones [e.g., salicylic acid (SA), jasmonic acid (JA), and ethylene (ET)] with the co-participation of mobile signals (e.g., glycerol-3-phosphate, azelaic acid, pipecolic acid, and N-hydroxy-pipecolic acid) (Kesel et al. 2021; Vlot et al. 2021; Zeier 2021). It is hoped that sustainable farming practices for the control of plant disease must include the use of IR stimuli (Siah et al. 2018). Considering the soybean-P. pachyrhizi pathosystem, the potential brought by different IR stimuli is very well documented in the literature (e.g., Bacillus subtilis, Metarhizium spp., cell wall extract of Saccharomyces cerevisiae, thaxtomin A from the Streptomyces scabies, harpin protein-derived peptides, saccharin, silicon, and nickel) to reduce rust severity at both greenhouse and field conditions through induction of defense reactions (Paula et al. 2021).
The present study hypothesized that a copper-polyphenolic compound sprayed onto soybean plants could increase their resistance against rust. This hypothesis was investigated by analyzing the photosynthetic apparatus and the role played by reactive oxygen species, antioxidant metabolism, and host defense responses of plants sprayed with the copper-polyphenolic compound and infected by P. pachyrhizi.
Materials and methods
In vitro assay
The effect of Mantus® [nitrogen (1%) and copper (20%) complexed with plant-derived pool of polyphenols (10%); FertiGlobal, Larderello, Italy] against the germination of P. pachyrhizi urediniospores was evaluated in vitro following the procedures of Picanço et al. (2022). Briefly, melted agar–agar (AA) medium was amended with Mantus® (2 mL/L AA medium) and 20 mL was poured into each Petri dish. Petri dishes containing only AA medium served as the control treatment. A total of 100 µl of urediniospores suspension (105 urediniospores/mL) from P. pachyrhizi was placed in the center of each Petri dish and homogeneously distributed using a Drigalski glass handle. Petri dishes were transferred to a growth chamber with conditions described by Picanço et al. (2022). After 24 h, 5 μl of lactophenol was added to each dish to halt urediniospore germination. One hundred urediniospores were randomly examined in each Petri dish under a light microscope. Urediniospores with germ tubes larger than their diameter were considered germinated (Picanço et al. 2022). The percentage of urediniospore germination was calculated for the replications of each treatment.
Plant growth conditions
Soybean plants [cultivar DS5916IPRO (https://www.brevant.com.br)] were grown in plastic pot (four plants per pot) containing 2 kg of a 1:1 mixture of soil and substrate and fertilized weekly (80 mL per pot) with the nutrient solution described by Picanço et al. (2022). Plants were grown in a greenhouse (temperature of 25 ± 2 °C, relative humidity of 70 ± 5%, and natural photosynthetically active radiation of 927 ± 20 μmol photons m−2 s−1 measured at midday).
Experimental design
For the in vitro assay, the experiment was arranged in a completely randomized design with two treatments (control and Mantus®) and ten replications. Each replication corresponded to one Petri dish. However, a 2 × 2 factorial experiment, consisting of plants sprayed with water (control) and Mantus® and non-inoculated or inoculated with P. pachyrhizi, was arranged in a completely randomized design with four replications per evaluation time to assess rust severity and the leaf gas exchange and chlorophyll a fluorescence parameters as well to determine photosynthetic pigment concentration. Leaf samples for the biochemical assays and gene expression analysis were obtained from another 2 × 2 factorial experiment with the same factors and arrangement described above. All experiments were repeated once.
Application of Mantus®
Soybean plants (V4 growth stage, ≈ 30 days after seedling emergence) were sprayed once with Mantus® [2 mL/L and 5 mL of solution per plant; referred to IR stimulus thereafter according to the criteria proposed by Kesel et al. (2021)] at 24 h before inoculation with P. pachyrhizi with the aid of a VL Airbrush atomizer. Plants sprayed with water served as the control treatment.
Plant inoculation with P. pachyrhizi
Soybean plants were inoculated with a suspension of 105 urediniospores/mL (5 mL of suspension per plant) of P. pachyrhizi using a VL Airbrush atomizer and transferred to a mist chamber (25 °C and 16 h under darkness) thereafter. After this period, plants were transferred to a greenhouse until the end of the experiments. Plants non-inoculated with P. pachyrhizi were kept in a different greenhouse under the same environmental conditions described above.
Evaluation of rust severity
The leaflets of the second and third leaves of each plant per replication of each treatment (four replications, 16 plants, and 32 leaves) were used to evaluate rust severity according to the diagrammatic scale proposed by Franceschi et al. (2020) at 5, 10, 15, and 20 days after inoculation (dai). The trapezoidal integration of disease progress curves for each leaflet per leaf of each plant from the replications of each treatment was used to calculate the area under disease progress curve (AUDPC) (Shaner and Finney 1977). At 20 dai, the second and third leaves of each plant per replication of each treatment were collected and scanned in a flatbed scanner (Epson Perfection model 19) at 600 dpi resolution (Epson Brasil, São Paulo, Brazil). The software QUANT (Fagundes-Nacarath et al. 2018) was used to process the images and obtain the final rust severity values.
Measurements of leaf gas exchange parameters
Leaf gas exchange parameters [net CO2 assimilation rate (A), stomatal conductance to water vapor (gs), internal CO2 concentration (Ci), and transpiration rate (E)] were determined on leaflets of the second leaf of each plant per replication of each treatment (four replications, 16 plants, and 16 leaves) by using a portable open-flow gas exchange system (LI-6400XT; Li-Cor Inc., Lincoln, NE) at 10 dai following the conditions described by Silva et al. (2022). At 10 dai, necrotic lesions containing uredinia were noticed on the leaflets of plants from control and IR stimulus treatments. Leaflets of the second leaf from non-inoculated plants were also evaluated at 10 dai.
Imaging and quantification of chlorophyll (Chl) a fluorescence parameters as well as determination of photosynthetic pigments concentration
Images and parameters of Chl a fluorescence were obtained from leaflets of the second leaf of each plant per replication of each treatment (four replications,16 plants, and 16 leaves) from both noninoculated and inoculated plants at 10 dai using the Imaging-PAM fluorometer and the Imaging Win software MAXI version (Heinz Walz GmbH, Effeltrich Germany) and following the procedures of Picanço et al. (2021). Five leaf discs (1 cm2 each) were obtained from the leaflets of the second and third leaves of each plant per replication of each treatment (four replications, 16 plants, and 32 leaves) at 5, 8, 11, and 14 dai. The discs were placed in glass tubes containing 5 ml of saturated dimethyl sulfoxide solution and calcium carbonate (5 g/L) and kept in the dark at room temperature for 24 h. The concentrations of Chl a, Chl b, and carotenoid were determined in the extracts according to Picanço et al. (2021).
Histochemical detection of reactive oxygen species (ROS) in leaf tissues
Hydrogen peroxide (H2O2) and superoxide anion radical (O2•−) were detected in leaf tissues following the procedures described by Aucique-Pérez et al. (2019). Leaflets of the second leaf of each plant per replication of each treatment (four replications, 8 plants, and 16 leaves) were collected at 9 dai. For H2O2 detection, 24 leaflets were randomly placed in glass vials containing 50 mL of a 3,3'-diaminobenzidine tetrahydrochloride (1 mg/mL) solution and kept in the darkness at 25 °C for 12 h. For O2•− detection, 24 leaflets were randomly placed in glass vials containing 50 mL of 0.1% solution of nitro blue tetrazolium solution in 10 mM potassium phosphate buffer (pH 6.8) and infiltrated for 24 h. Leaflets were cleared in 80% of boiling aqueous ethanol solution for 60 min until brown and blue spots were noticed as an indication of H2O2 and O2•− depositions, respectively.
Biochemical assays and gene expression using quantitative PCR
The second and third leaves of each plant per replication of each treatment (four replications, 16 plants, and 32 leaves) were collected at 2, 3, 5, and 9 dai (for biochemical assays) and at 1, 2, 3, 5, and 9 dai (for gene expression analysis) from both non-inoculated and inoculated plants. Leaf samples were kept in liquid nitrogen during sampling and stored at -80ºC until further analysis (Picanço et al. 2021).
Determining antioxidant enzymes activity
Leaf tissue (0.2 g) was ground into a fine powder with liquid nitrogen using a vibration ball mill (Retsch, Haan, Germany) and homogenized in 2 ml of a solution containing potassium phosphate buffer (50 mM, pH 6.8), ethylenediaminetetraacetic acid (0.1 mM), phenylmethylsulfonyl fluoride (1 mM), and polyvinylpyrrolidone (2% w/v) following centrifugation at 12,000 g for 15 min at 4 °C. Activities of ascorbate peroxidase (APX) (Enzyme Commission (EC) Number 1.11.1.11), catalase (CAT) (EC Number 1.11.1.6), peroxidase (POX) (EC Number 1.11.1.7), superoxide dismutase (SOD) (EC Number 1.15.1.1), and glutathione reductase (GR) (EC Number 1.8.1.7) were determined in the supernatant according to Dias et al. (2020).
Determining total soluble phenolics (TSP) and lignin-thioglycolic acid (LTGA) derivatives concentrations
Leaf tissue (0.1 g) was ground as described above and the fine powder was homogenized in 1 mL of methanol solution (80% v/v). The crude extract was shaken (300 rpm for 2 h at 25 °C) and the mixture was centrifuged at 17,000 g for 30 min. The TSP concentration was determined in the methanolic extract and the pellet was used to determine the LTGA derivatives concentration according to Picanço et al. (2021).
Gene expression
Leaf tissue (75 mg) was ground as described above and the procedures described by Picanço et al. (2022) related to RNA (extraction, determination of its quality and integrity, and quantification) and cDNAs synthesis were used. A Bio-Rad CFX Real Time Thermal Cycler was used for the qRT-PCR. All reactions used the SYBR Green PCR Master Mix and were performed in duplicate. Specific primers were synthesized (Life Technologies, São Paulo, Brazil) and used to determine the expression of genes encoding for phenylalanine ammonia-lyase (PAL1.1, PAL1.3, PAL2.1, and PAL3.1), chitinase (CHIA1), chalcone isomerase (CHI1B1), lipoxygenase (LOX), pathogenesis-related protein 1 (PR1-A), pathogenesis-related protein 10 (PR10), metalloproteinase (MMP2), urease (URE), isochorismate synthase (ICS1 and ICS2), and jasmonic acid-amino synthetase (JAR1) (Table S1). The expression of TEF-1α, corresponding to the translation elongation factor 1α of P. pachyrhizi, was also quantified to confirm its presence in plant tissues. The Ubiquitin-3 (UBIQ) and glyceraldehyde-3-phosphate dehydrogenase (GAPDH) genes were used as a reference for normalization as proposed by van de Mortel et al. (2007). The 2−ΔΔCt method (Livak and Schmittgen 2001) was used to calculate the relative expression values for each gene studied.
Data analysis
Data from the variables and parameters evaluated from the repeated experiments were combined according to Moore and Dixon (2015), checked for normality and homogeneity of variance, and subjected to analysis of variance. Treatments means for urediniospore germination were compared by the F test (P ≤ 0.05). For other variables and parameters, means for control and IR stimulus treatments as well as non-inoculated and inoculated plants were compared by the F test (P ≤ 0.05). Data from variables and parameters from four treatments (plants non-inoculated or inoculated with P. pachyrhizi from control and IR stimulus treatments) at 10 dai was used to generate the principal components analysis. The Minitab Statistical software was used for the statistical analysis (Minitab 2023).
Results
Analysis of variance
The impact of conducted treatments such as IR stimulus as well as control (water) [named as products (P)] on urediniospores germination was analyzed by one-way ANOVA. The factor P was significant (P < 0.001) for the germination of urediniospores. The response of all variables and parameters to P, plant inoculation (PI), and the P × PI interaction was analyzed by a two-way ANOVA. The factor P and the P × PI interaction were significant (P ≤ 0.05) for most of the variables and parameters studied (Table S2).
Evaluation of urediniospores germination in vitro
Germination of urediniospores on AA medium amended with IR stimulus was significantly reduced by 97% compared to control treatment (Fig. 1).
Urediniospore germination of Phakopsora pachyrhizi in Petri dishes containing agar–agar medium non-amended (control) or amended with induced resistance (IR) stimulus. The asterisk (*) indicates a significant difference between treatments according to the F test (P ≤ 0.05). Bars represent the standard error of the means
Rust symptoms, AUDPC, and rust severity
Necrotic lesions containing uredinia were abundant on the leaflets of control plants in contrast to the leaflets from plants sprayed with the IR stimulus (Fig. 2a-b). The AUDPC significantly decreased by 35% with IR stimulus-sprayed plants compared to control plants (Fig. 2c). Rust severity estimated by the QUANT software was significantly reduced by 68% for plants sprayed with IR stimulus compared to control plants (Fig. 2d).
Rust symptoms (chlorosis and necrosis) and sporulation of Phakopsora pachyrhizi in the abaxial surface of leaflets from soybean plants sprayed with water (control) (A) or with induced resistance (IR) stimulus (B). Area under disease progress curve (AUDPC) (C) and severity (D) for soybean plants sprayed with water (control) or with induced resistance (IR) stimulus. The asterisk (*) indicates a significant difference between treatments (C and D) according to the F test (P ≤ 0.05). Bars represent the standard error of the means
Parameters of leaf gas exchange
Photosynthesis on diseased leaves was less impaired for IR stimulus-sprayed plants (significative increases of 28, 40, and 28% for A, gs, and E, respectively) compared to control plants (Fig. 3a-b and d). Non-diseased leaves displayed better photosynthetic performance (significant increases of 52, 53, and 37% for A, gs, and E, respectively) compared to diseased leaves of control plants (Fig. 3a-b and d). For the IR stimulus-sprayed plants, A significantly increased by 30% for non-diseased leaves compared to diseased leaves, while Ci significantly increased by 3% for diseased leaves compared to non-diseased leaves (Fig. 3a and c).
Leaf gas exchange parameters net CO2 assimilation rate (A) (A), stomatal conductance to water vapor (gs) (B), internal CO2 concentration (Ci) (C), and transpiration rate (E) (D) determined on the leaflets of soybean plants non-inoculated (NI) or inoculated (I) with Phakopsora pachyrhizi and sprayed with water (control) or with induced resistance (IR) stimulus. Means for NI and I treatments followed by an asterisk (*) and for control and IR stimulus treatments followed by an inverted triangle (▼) are significantly different according to the F test (P ≤ 0.05). Bars represent the standard deviation of the means. Data shown are from 10 days after non-inoculation or inoculation of plants with P. pachyrhizi
Imaging and quantification of Chl a fluorescence parameters
Damage to the photosynthetic apparatus of control plants compared to IR stimulus-sprayed plants occurred at 10 dai based on the darker areas in the images for Fv/Fm (maximum PSII quantum efficiency), Y(II) (photochemical yield), Y(NPQ) (yield for dissipation by down-regulation), and Y(NO) (yield for non-regulated dissipation) parameters (Fig. 4). In general, IR stimulus-sprayed plants faced P. pachyrhizi infection more efficiently based on the outcome of Chl a fluorescence parameters. For non-inoculated plants, Y(NO) was significantly higher by 23% for IR stimulus-sprayed plants compared to control plants (Fig. 5d). For inoculated plants, Y(II) and ETR (electron transport rate) were significantly greater by 56 and 51%, respectively, while Y(NPQ) and Y(NO) were significantly lower by 14 and 37%, respectively, for IR stimulus-sprayed plants compared to control plants (Fig. 5b-e). Regarding the control plants, Y(II) and ETR were significantly higher by 56 and 50%, respectively, for non-inoculated plants compared to inoculated plants, while Y(NO) was significantly reduced by 39% for inoculated plants compared to non-inoculated plants (Fig. 5b and d-e). For IR stimulus-sprayed plants, Y(NO) was significantly higher by 20% for non-inoculated plants compared to inoculated plants (Fig. 5d).
Images of chlorophyll a fluorescence parameters maximum PSII quantum efficiency (Fv/Fm), photochemical yield (Y(II)), yield for dissipation by down-regulation (Y(NPQ)), and yield for non-regulated dissipation (Y(NO)) obtained from leaflets of soybean plants sprayed with water (control) or with induced resistance (IR) stimulus and non-inoculated (NI) or at 10 days after inoculation (I) with Phakopsora pachyrhizi
Quantification of chlorophyll a fluorescence parameters maximum PSII quantum efficiency (Fv/Fm) (A), photochemical yield (Y(II)) (B), yield for dissipation by down-regulation (Y(NPQ)) (C), yield for non-regulated dissipation (Y(NO)) (D), and electron transport rate (ERT) (E) on the leaflets of soybean plants non-inoculated (NI) or inoculated (I) with Phakopsora pachyrhizi and sprayed with water (control) or with induced resistance (IR) stimulus. Means for NI and I treatments followed by an asterisk (*) and for control and IR stimulus treatments followed by an inverted triangle (▼) are significantly different according to the F test (P ≤ 0.05). Bars represent the standard deviation of the means. Data shown are from 10 days after non-inoculation or inoculation of plants with P. pachyrhizi
Concentration of photosynthetic pigments
For non-inoculated plants, Chl a + b and carotenoid concentrations significantly increased by 12% for IR stimulus-sprayed plants compared to control plants at 11 dai (Fig. 6a and c). For inoculated plants, concentrations of Chl a + b (69% at 14 dai) and carotenoid (19 and 27% at 8 and 14 dai, respectively) were significantly higher for IR stimulus-sprayed plants compared to control plants (Fig. 6b and d). In general, Chl a + b and carotenoid concentrations were significantly higher for non-inoculated plants compared to inoculated plants from control plants and IR stimulus-sprayed plants during the time-course evaluated (Fig. 6a-d).
Concentrations of chlorophyll a + b (Chl a + b) (A and B) and carotenoid (C and D) determined on the leaflets of soybean plants non-inoculated (A and C) or inoculated (B and D) with Phakopsora pachyrhizi and sprayed with water (control) or with induced resistance (IR) stimulus. Means for NI and I treatments followed by an asterisk (*) and for control and IR stimulus treatments followed by an inverted triangle (▼), at each sampling time, are significantly different according to the F test (P ≤ 0.05). Bars represent the standard deviation of the means
Histochemical localization of H2O2 and O2 •−
Leaflets from non-inoculated plants sprayed with the IR stimulus did not show any sign of cellular perturbation based on the absence or weak staining for H2O2 and O2•− detections compared to control plants (Figs. 7a-b and 8a-b). Depositions of H2O2 (brown color) and O2•− (blue color) were less remarkably intense in leaflets of inoculated plants from IR stimulus-sprayed plants (Figs. 7d and 8d) compared to control plants (Figs. 7b and 8b).
Histochemical detection of hydrogen peroxide on the leaflets of soybean plants non-inoculated (A and B) or inoculated (C and D) with Phakopsora pachyrhizi and sprayed with water (control) (A and C) or with induced resistance (IR) stimulus (B and D). The leaflets were sampled 15 days after non-inoculation or inoculation of plants with P. pachyrhizi
Histochemical detection of superoxide anion radical on the leaflets of soybean plants non-inoculated (A and B) or inoculated (C and D) with Phakopsora pachyrhizi and sprayed with water (control) (A and C) or with induced resistance (IR) stimulus (B and D). The leaflets were sampled 15 days after non-inoculation or inoculation of plants with P. pachyrhizi
Activities of antioxidant enzymes
Non-diseased and IR-stimulus-sprayed plants showed a more operant antioxidant metabolism (significant increases of 37 and 30% at 3 dai for SOD and POX activities, respectively, and significant decreases of 44 and 65% at 2 dai for CAT and GR activities, respectively) compared to control plants (Fig. 9a, c, e, and i). Diseased and IR stimulus-sprayed plants also showed a similar trend [significant increases for SOD (44 and 31%, respectively, at 3 and 5 dai) and POX (51% at 5 dai) activities and significant decreases for POX (56 and 64%, respectively, at 2 and 9 dai), CAT (70% at 9 dai), APX (60 and 64%, respectively, at 3 and 9 dai), and GR (74% at 9 dai) activities] compared to diseased plants from the control treatment (Fig. 9b, d, f, h, and j). Diseased leaves displayed significant increases in SOD, POX, CAT, APX, and GR activities compared to non-diseased leaves for control plants and IR stimulus-sprayed plants, especially for the former, from 2 to 9 dai (Fig. 9a-j).
Activities of superoxide dismutase (SOD) (A and B), peroxidase (POX) (C and D), catalase (CAT) (E and F), ascorbate peroxidase (APX) (G and H), and glutathione reductase (GR) (I and J) determined on the leaflets of soybean plants non-inoculated (A, C, E, G, and I) or inoculated (B, D, F, H, and J) with Phakopsora pachyrhizi and sprayed with water (control) or with induced resistance (IR) stimulus. Means for NI and I treatments followed by an asterisk (*) and for control and IR stimulus treatments followed by an inverted triangle (▼), at each sampling time, are significantly different according to the F test (P ≤ 0.05). Bars represent the standard deviation of the means
Concentrations of TSP and LTGA derivatives
The concentrations of TSP and LTGA derivatives for non-inoculated plants and the TSP concentration for inoculated plants were not affected for control plants and IR stimulus-sprayed plants regardless of evaluation time (Fig. 10a-c). For inoculated plants, LTGA derivatives concentration was significantly lower by 9% for IR stimulus-sprayed plants compared to control plants at 9 dai (Fig. 10d). The concentration of LTGA derivatives was significantly higher for inoculated plants compared to non-inoculated plants for control plants and IR stimulus-sprayed plants from 3 to 9 dai (Fig. 10c-d).
Concentrations of total soluble phenolics (TSP) (A and B) and lignin-thioglycolic acid (LTGA) derivatives (C and D) determined on the leaflets of soybean plants non-inoculated (A and C) or inoculated (B and D) with Phakopsora pachyrhizi and sprayed with water (control) or with induced resistance (IR) stimulus. Means for NI and I treatments followed by an asterisk (*) and for control and IR stimulus treatments followed by an inverted triangle (▼), at each sampling time, are significantly different according to the F test (P ≤ 0.05). Bars represent the standard deviation of the means. FW and DW = fresh and dry weight, respectively
Gene expression
Comparing NI vs. I plants for control and IR stimulus treatments
Expressions of PAL1.1, PAL1.3, PAL2.1, PAL3.1, CHIA1, CHIB1, PR1-A, PR10, and MMP2 at 1 dai, PAL1.1, CHIA1, PR1-A, and MMP2 at 2 dai, MMP2 at 3 dai, and PAL1.1 and PR10 at 5 dai were significantly up-regulated for inoculated plants compared to non-inoculated plants for control treatment. Expressions of ICS1 at 1 dai, LOX at 2 dai, and CHIB1 at 5 dai were significantly down-regulated for inoculated plants compared to non-inoculated plants for control treatment (Fig. 11a and c). Expressions of PAL1.1, PAL1.3, PAL3.1, CHIA1, PR1-A, ICS1, and JAR1 at 1 dai, PAL1.1, CHIA1, and PR1-A at 2 dai, PAL1.3, PAL3.1, CHIA1, PR1-A, PR10, ICS1, and JAR1 at 3 dai, PAL3.1, CHIA1, CHIB1, and PR10 at 5 dai were significantly up-regulated for inoculated plants compared to non-inoculated plants for IR stimulus treatment. Expressions of LOX at 1 and 5 dai and URE at 1 and 2 dai were significantly down-regulated for inoculated plants compared to non-inoculated plants for IR stimulus treatment (Fig. 11b and d).
Expression profile of genes determined in leaflets of soybean plants non-inoculated (NI) (A and B) or inoculated (I) (C and D) with Phakopsora pachyrhizi and sprayed with water (control) (A and C) or with induced resistance (IR) stimulus (B and D). Color cells ranging from blue (-4.0) to red (4.0) represent the relative transcript levels for the genes studied. Amplifications of Ubiquitin-3 (UBIQ) and glyceraldehyde 3-phosphate dehydrogenase (GAPDH) genes from soybean were used as internal controls for data normalization. Fold changes were calculated based on the transcript level for NI plants of the control treatment at 1 day after inoculation. For each leaf sample, four biological replications were used with their respective two technical replicates. Means for NI and I plants for control and IR stimulus treatments, at each evaluation time, followed by an asterisk (*) are significantly different (P ≤ 0.05) according to the F test. A triangle (▲) indicates a significant difference between control and IR stimulus treatments for NI and I plants, at each evaluation time, according to the F test (P ≤ 0.05)
Comparing IR stimulus and control treatments for NI and I plants
Non-inoculated plants: expressions of PAL3.1, CHIB1, PR1-A, PR10, and JAR1 were significantly up-regulated at 1 dai, while PAL1.1, CHIB1, and LOX were significantly down-regulated at 1, 5, and 2 dai, respectively, for IR stimulus treatment compared to control treatment (Fig. 11a-b).
Inoculated plants: expressions of PAL1.3 and ICS1 at 1 dai, PAL1.1, PAL1.3, PAL3.1, CHIA1, LOX, PR10, ICS1, and JAR1 at 3 dai, as well as CHIB1 at 5 dai were significantly up-regulated, while LOX and PR10 at 1 dai, ICS2 at 3 dai as well as PAL1.1 and PAL1.3 at 5 dai were significantly down-regulated for IR stimulus treatment compared to control treatment (Fig. 11c-d). Expression of TEF-1α was significantly down-regulated at 1 and 2 dai for IR stimulus treatment compared to control treatment (Fig. 11c-d).
PCA analysis
One principal component (PC) explained most of data variation (PC1 = 59.4% and PC2 = 28.7%) (Fig. 12a-b). Four cluster groups (NI control, I control, NI IR stimulus, and I IR stimulus treatments) were delineated according to cluster analysis with complete linkage and Pearson distances (Fig. 12a). The PC1 resulted in negative scores for photosynthetic parameters [Fv/Fm, Y(II), and ETR], photosynthetic measurements (A, E, and gs), Chl a + b, Car, and for the expression of some genes (URE, CHI1B1, PAL1.3, PR1-A, ICS1, ICS2, and LOX), and positive scores for other variables and parameters evaluated (Fig. 12b). The PC2 was characterized by negative scores for AUDPC, photosynthetic parameters [A, gs, E, Y(NPQ), and Y(NO)], LTGA derivatives, antioxidant enzymes (SOD, POX, CAT, APX, and GR) and for the expression of some genes (PAL1.1, PAL1.3, PAL2.1, PAL3.1, LOX, PR1-A, PR10, ICS1, ICS2, and JAR1) and positive scores for other variables and parameters evaluated (Fig. 12b).
Score plots (a) and loading (b) values in the principal component analysis (PCA) for variables and parameters evaluated in soybean plants non-inoculated (NI) or inoculated (I) with Phakopsora pachyrhizi and sprayed with water (control) or with induced resistance (IR) stimulus. Numbers in the loading plot (b) are as follow: severity (1), area under disease progress curve (2), leaf gas exchange parameters (3, 4, 5, and 6 = net CO2 assimilation rate, stomatal conductance to water vapor, internal CO2 concentration, and transpiration rate, respectively), chlorophyll a fluorescence parameters (7, 8, 9, 10, and 11 = maximum PSII quantum yield, effective PSII quantum yield, quantum yield of regulated energy dissipation, quantum yield of non-regulated energy dissipation, and electron transport rate, respectively), photosynthetic pigments (12 and 13 = chlorophyll a + b and carotenoid, respectively), activities of antioxidant enzymes (14, 15, 16, 17, and 18 = superoxide dismutase, peroxidase, catalase, ascorbate peroxidase, and glutathione reductase, respectively), total soluble phenolics (19), lignin-thioglycolic acid derivatives (20), and genes expression (21, 22, 23, 24, 25, 26, 27, 28, 29, 30, 31, 32, 33, and 34 = PAL1.1, PAL1.3, PAL2.1, PAL3.1, CHIA1, CHI1B1, LOX, PR1-A, PR10, MMP2, URE, ICS1, ICS2, and JAR1, respectively). Groups were generated from cluster analysis with complete linkage and Pearson distance. Data from variables and parameters used in the PCA analysis were obtained for NI and I plants at 10 days
Discussion
The routinely usage of fungicides for managing soybean rust caused development in the resistance of P. pachyrhizi (Klosowski et al. 2018), therefore, using IR stimuli becomes an eco-friendly and sustainable alternative for integrated rust management. In the present study, rust symptoms and the fungal colonization of leaf tissues were greatly reduced for IR stimulus-sprayed plants. Even though the IR stimulus showed antifungal activity against urediniospores in vitro, it also was able to trigger soybean defense responses against fungal infection. In fact, some IR stimuli reported in the literature [e.g., acibenzolar-S-methyl (ASM)] may exert a fungicide effect against some pathogens by inhibiting mycelial growth or spore germination rather than only eliciting or prime host defense reactions (Siah et al. 2018; Mejri et al. 2021; Mohammad et al. 2021; Paula et al. 2021).
Increased susceptibility of plants against pathogens of different lifestyles is closely associated with photosynthetic impairment and their less capacity for a prompt defense response due to profound alterations in the translocation of photoassimilates across organs (Debona et al. 2014; Silveira et al. 2015; Rios et al. 2014; Dias et al. 2020; Sterling and Melgarejo 2021). Particularly in soybean, leaf infection by P. pachyrhizi seriously compromises photosynthesis as pictured by remarkable changes in leaf gas exchange (lower A, gs, Ci, and E) and Chl a fluorescence [lower Fv/Fm, Y(II), and Y(NPQ) followed by increases in Y(NO)] parameters along with reduced Chl a + b and carotenoid concentrations (Rios et al. 2018). In the present study, photosynthesis was remarkably preserved in diseased leaves of IR stimulus-sprayed plants. Great A, gs, and E values obtained for diseased leaves of IR stimulus-sprayed plants reflected their better physiological status due to less biochemical and diffusional limitations associated with great preservation of stomata functionality during infection by P. pachyrhizi. A balance between the electron flow and CO2 assimilation during photosynthesis occurred for diseased leaves of IR stimulus-sprayed plants considering the greatest values for A and ETR. On top of that, diseased leaves of IR stimulus-sprayed plants suffered less photodamage [e.g., higher Y(II) values and reductions in Y(NPQ) and Y(NO)] at the photosynthetic machinery level. Linked to that, ETR was higher while Y(NPQ) was lower indicating that heat dissipation to alleviate any damage imposed on PSII was minimal and ensured even more preservation of the photosynthetic apparatus. Interestingly, damage to the reaction centers associated with the photosystems based on Fv/Fm values was similar between control plants and IR stimulus-sprayed plants regardless of P. pachyrhizi infection. High photosynthetic pigment (Chl a + b at 14 dai and carotenoid at 8 and 14 dai) concentration was noticed for diseased leaves of IR stimulus-sprayed plants due to reduction in rust development indicating that light energy was used more efficiently towards improved photosynthesis. Interestingly, Chl a + b and carotenoid concentrations were higher for IR-stimulus plants compared to control plants not challenged with P. pachyrhizi at 11 dai. Different IR stimuli can mitigate the stress imposed by foliar pathogens on photosynthesis of their hosts, including the soybean-P. pachyrhizi interaction due to the activation of defense responses that affect disease development than just having a fungistatic effect (Rios et al. 2014; Fagundes-Nacarath et al. 2018; Aucique-Pérez et al. 2019; Dias et al. 2020; Einhardt et al. 2020; Picanço et al. 2022).
The cellular damage caused by ROS accumulation is well-documented in plant tissues infected by pathogens (Low and Merida 1996). A well-coordinated enzymatic system in the cell wall, plasma membrane, and symplast of leaves diseased by pathogens play a key role in scavenging the excess of ROS generated (Das and Roychoudhury 2014). In contrast to IR stimulus-sprayed plants, control plants displayed increased POX, CAT, APX, and GR activities in response to P. pachyrhizi infection. Interestingly, higher SOD activity in the leaves of IR stimulus-sprayed and diseased plants was higher at 3 and 5 dai helped to decrease the pool of O2•− which was also histochemically confirmed. Beyond that, the great amount of H2O2 generated as a result of increased SOD activity did not seem to exert a harmful effect in diseased leaves of IR stimulus sprayed plants considering the reduction on rust development. In this scenario, CAT, APX, and GR (except POX at 5 dai) activities did not increase to scavenge H2O2 and the foliar presence of H2O2 was minimal. On the other hand, lower GR activity for IR stimulus-sprayed and diseased plants was possibly linked to less production of other ROS (e.g., singlet oxygen and hydroxyl radical) in contrast to higher activity obtained for diseased plants of the control treatment at 9 hai. It is important to point out that the IR stimulus was efficient to reduce the oxidative stress imposed by P. pachyrhizi infection without imposing a high metabolic cost on soybean plants as denoted by the slight changes on the photosynthetic apparatus. More than a possible harmful effect of the transitional pool of H2O2, indirectly associated with higher SOD activity, for IR stimulus-sprayed and diseased plants, its role as a signaling molecule to activate defense responses in plants expressing SAR to cope with pathogen infection (Low and Merida 1996) cannot be ruled out. Plants are prone to develop a more robust and transient antioxidative metabolism to mitigate the stress at the infection sites of the pathogen after being in contact to IR stimuli (Rios et al. 2014; Fagundes-Nacarath et al. 2018; Aucique-Pérez et al. 2019; Dias et al. 2020; Einhardt et al. 2020; Mohammad et al. 2021; Paula et al. 2021).
The action of the IR stimulus in boosting soybean resistance against rust was investigated at the molecular level by examining the expression of some defense-related genes. Interestingly, in the absence of P. pachyrhizi infection, earlier up-regulation of PAL3.1, CHIB1, PR1-A, PR10, and JAR1 for IR stimulus-sprayed plants indicated elicitation of defense responses. Notably, the gene expression pattern was strikingly similar for inoculated plants but sometimes more remarkable for IR stimulus-sprayed plants than control plants. In this context, up-regulation of PAL1.1, PAL3.1, CHIA1, LOX, PR10, and JAR1 at 3 dai, PAL1.3 at 1 dai, ICS1 at 3 dai, and CHIB1 at 5 dai for IR stimulus-sprayed plants was closely linked to their increased resistance against rust. Interestingly, the level of response gained by the IR stimulus in boosting soybean defense reactions against P. pachyrhizi infection was comparable to the ASM (a very-well recognized inducer of resistance), a phosphite combined with free amino acids (Picanço et al. 2022), and other IR stimuli reported by Paula et al. (2021). The IR stimuli have great potential to elicit or prime plants, previously exposed to them, to cope with pathogen infection in a faster, more effective, and more extended period due to the involvement of different defense reactions (pathogenesis-related proteins (e.g., chitinases, β-1,3-glucanases, PR1, and PR10), antimicrobial compounds (e.g., phenolics, quinones, phytoalexins, and some peptides), and lignification of plant tissues) (Kesel et al. 2021; Vlot et al. 2021). An increase in TSP concentration or even their subsequent polymerization towards lignin production (except higher LTGA derivatives concentration for control plants compared to IR stimulus-sprayed plants at 9 dai) was not linked to PAL expression on diseased plants from control or IR stimulus treatments. In some cases, soybean plants counteract P. pachyrhizi infection by increasing the production of either phenolics or lignin which seems to be greatly affected by the type of IR stimulus (Einhardt et al. 2020; Paula et al. 2021; Picanço et al. 2021, 2022). In soybean, the enzyme chalcone isomerase, encoded by CHIB1, synthesizes different flavonoids (Kim and Chung 2007). The IR stimulus-sprayed plants dependent on the flavonoid pathway considering the up-regulation of CHIB1 to fight against rust. Park (2010) reported that transcripts for CHI1, coding for chalcone isomerase 1, was abundantly produced in soybean leaves infected by P. pachyrhizi at 10 hai.
Soybean resistance against soilborne and foliar diseases caused by pathogens of different lifestyles activate ISR or SAR after being exposed to IR stimuli (Paula et al. 2021). It is reasonable to assume that the IR stimulus used in the present study was able to prime both SA and JA signaling pathways to cope with the harmful effect of P. pachyrhizi infection. Taking into consideration the particularity of symptoms caused by P. pachyrhizi on soybean leaves (necrosis) in contrast to those caused by other fungi causing rust (e.g., Uromyces appendiculatus in common beans—absence of necrosis and discrete chlorosis at the infection sites), it is expected plants will be prone to develop SAR. However, at some point in the P. pachyrhizi infection process, a necrotrophic phase can take place over the biotrophic lifestyle to manipulate the immune system of soybean plants with effectors released in favor of successful infections (Barros et al. 2020). In soybean, SA is originated from either phenylpropanoid or isochorismate pathways in which PAL and ICS, respectively, are involved (Shine et al. 2016). It is tempting to speculate that SA originated from both phenylpropanoid and isochorismate pathways were important for the increased resistance of IR stimulus-sprayed and diseased plants through SAR activation considering the more substantial up-regulation of PAL1.1 and PAL3.1 (at 3 dai) as well as PAL1.3 and ICS1 (at 1 and 3 dai). In many plant-pathogen interactions, JAR1 expression has been used as a molecular marker to check the activation of JA pathway while PR1 is often up-regulated in diseased plants exhibiting SAR (Feys and Parker 2000; Kesel et al. 2021). However, in the present study, increased resistance of IR stimulus-sprayed plants against rust cannot be attributed exclusively on PR1-A, but taking into consideration a holistic role played by other genes (e.g., PAL and ICS). Indeed, there was no difference between diseased plants from control or IR stimulus treatments regarding PR1-A expression. Paula et al. (2022) reported that reduction in rust severity in soybean plants by thaxtomin A involved ET (up-regulation of ACC) with no apparent effect of SA pathway based on down-regulation of PR1, NPR1, and MeSA. The up-regulation of JAR1 for IR stimulus-sprayed and diseased plants at 3 dai shed light on the possible contribution of ISR in soybean resistance against rust. The decision of plants to follow either the SA or the JA/ET pathway, or having their co-participation at some stage of the pathogen infection process, is often linked to the type of IR stimulus used (rate and time of application), the level of resistance of the cultivar, and the pathogen lifestyle in an attempt to allocate the metabolic energy as more efficiently as possible (Siah et al. 2018; Vlot et al. 2021; Zeier 2021). There were no clear pieces of evidence for the involvement of LOX, PR10, MMP2, and URE on the resistance of IR stimulus sprayed and diseased plants. Interestingly, for the soybean-P. pachyrhizi interaction, Park (2010) reported that PR10 was one of the 40 proteins differentially expressed until 10 dai and PR10 expression was significantly up-regulated (at 10 hai as well as at 6 and 8 days after inoculation) in diseased leaves from plants of a susceptible cultivar. The PR10 was also up-regulated in soybean leaves previously exposed to SA, ethylene, abscisic acid, and JA and infected by Phytophthora sojae (Jiang et al. 2015).
In conclusion, a body of evidences were reported in the present study that highlights the potential of the copper-polyphenolic compound to increase soybean resistance against rust. Based on the PCA analysis, soybean plants infected by P. pachyrhizi responded differently after being sprayed with water or IR stimulus. In this regard, IR stimulus-sprayed plants had a more preserved photosynthetic apparatus (more energy to be allocated for biochemical pathways involved in host defense reactions), expressive defense response (up-regulation of genes related to host basal defense and signaling pathways mediated by SA and JA), and a robust antioxidative metabolism to face P. pachyrhizi infection more efficiently. It is tempting to assume that using this IR stimulus, associated with available control strategies, may become a promising alternative through a defense-stimulating effect to help reduce fungicides spray and avoid yield losses caused by rust.
Data availability
Data will be made available on reasonable request.
References
Aucique-Pérez CE, Resende RS, Neto LBC, Dornelas F, DaMatta FM, Rodrigues FA (2019) Picolinic acid spray stimulates the antioxidative metabolism and minimizes impairments on photosynthesis on wheat leaves diseased by Pyricularia oryzae. Physiologia Plantarum 167:628–644
Barros VA, Fontes PP, Souza GB, Gonçalves AB, Carvalho K, Rincão MP, Lopes ION, Costa MDL, Alves MS, Marcelino-Guimarães FC (2020) Phakopsora pachyrhizi triggers the jasmonate signaling pathway during compatible interaction in soybean and GmbZIP89 plays a role of major component in the pathway. Plant Physiology and Biochemistry 151:526–534
Das K, Roychoudhury A (2014) Reactive oxygen species (ROS) and response of antioxidants as ROS-scavengers during environmental stress in plants. Frontiers in Environmental Science 2:53
Debona D, Rodrigues FA, Rios JA, Martins SCV, Pereira LF, DaMatta FM (2014) Limitations to photosynthesis in leaves of wheat plants diseased by Pyricularia oryzae. Phytopathology 104:34–39
Dias CS, Rios JA, Einhardt AM, Chaves JAA, Rodrigues FA (2020) Effect of glutamate on Pyricularia oryzae infection of rice monitored by changes in photosynthetic parameters and antioxidant metabolism. Physiologia Plantarum 169:179–193
Einhardt AM, Ferreira S, Hawerroth C, Valadares SV, Rodrigues FA (2020) Nickel potentiates soybean resistance against infection by Phakopsora pachyrhizi. Plant Pathology 69:849–859
Fagundes-Nacarath IRF, Debona D, Rodrigues FA (2018) Oxalic acid-mediated biochemical and physiological changes in the common bean-Sclerotinia sclerotiorum interaction. Plant Physiology and Biochemistry 129:109–121
Feys BJ, Parker JE (2000) Interplay of signaling pathways in plant disease resistance. Trends in Genetics 16:449–455
Franceschi VT, Alves KS, Mazaro SM, Godoy CV, Duarte HSS, Del Ponte EM (2020) A new standard area diagram set for assessment of severity of soybean rust improves accuracy of estimates and optimizes resource use. Plant Pathology 69:495–505
Hartman GL, West ED, Herman TK (2011) Crops that feed the World 2. Soybean-worldwide production, use, and constraints caused by pathogens and pests. Food Security 3:5–17
Jiang L, Wu J, Fan S, Li W, Dong L, Cheng Q (2015) Isolation and characterization of a novel pathogenesis-related protein gene (GmPRP) with induced expression in soybean (Glycine max) during infection with Phytophthora sojae. PLoS ONE 10:e0129932
Kesel J, Conrath U, Flors V, Luna E, Mageroy MH, Mauch-Mani B, Pastor V, Pozo MJ, Pieterse CMJ, Ton J, Kyndt T (2021) The induced resistance lexicon: do’s and don’ts. Trends in Plant Science 26:685–691
Kim JA, Chung IM (2007) Change in isoflavone concentration of soybean (Glycine max L.) seeds at different growth stages. Journal of the Science of Food and Agriculture 87:496–503
Klosowski AC, Castellar C, Stammler G, May de Mio LL (2018) Fungicide sensitivity and monocyclic parameters related to the Phakopsora pachyrhizi-soybean pathosystem from organic and conventional soybean production systems. Plant Pathology 67:1697–1705
Langenbach C, Campe R, Beyer SF, Mueller AN, Conrath U (2016) Fighting Asian soybean rust. Frontiers of Plant Science 7:797
Livak KJ, Schmittgen TD (2001) Analysis of relative gene expression data using real-time quantitative PCR and the 2-∆∆CT method. Methods 25:402–408
Low PS, Merida JR (1996) The oxidative burst in plant defense: function and signal transduction. Physiologia Plantarum 96:533–542
Mejri S, Magnin-Robert M, Randoux B, Ghinet A, Halama P, Siah A, Reignault P (2021) Saccharin provides protection and activates defense mechanisms in wheat against the hemibiotrophic pathogen Zymoseptoria tritici. Plant Disease 105(780):786
Minitab LLC (2023) Minitab. Retrieved from https://www.minitab.com
Mohammad MA, Cheng Y, Aslam M, Jakada BH, Wai MH, Ye K (2021) ROS and oxidative response systems in plants under biotic and abiotic stresses: revisiting the crucial role of phosphite triggered plants defense response. Frontiers in Microbiology 12:631318
Moore KJ, Dixon PM (2015) Analysis of combined experiments revisited. Agronomy Journal 107:763–771
Park S (2010) Study of host-fungus interactions between soybean and Phakopsora pachyrhizi using proteomics. Louisiana State University. Doctoral Dissertations 3217
Paula S, Dalio RJD, Maximo HJ, Pino LE, Amorim DJ, Paz SMR, Brandão DFR, Demétrio CGB, Pascholati SF (2022) Potential of thaxtomin A for the control of the Asian soybean rust. Canadian Journal of Plant Pathology 44:56–65
Paula S, Holz S, Souza DHG, Pascholati SF (2021) Potential of resistance inducers for soybean rust management. Canadian Journal of Plant Pathology 43:298–307
Picanço BBM, Ferreira S, Fontes BA, Oliveira LM, Silva BN, Einhardt AM, Rodrigues FA (2021) Soybean resistance to Phakopsora pachyrhizi infection is barely potentiated by boron. Physiological and Molecular Plant Pathology 115:101668
Picanço BBM, Silva BN, Rodrigues FA (2022) Potentiation of soybean resistance against Phakopsora pachyrhizi infection using phosphite combined with free amino acids. Plant Pathology 71:1496–1510
Rios JA, Rodrigues FA, Debona D, Resende RS, Moreira WR, Andrade CCL (2014) Induction of resistance to Pyricularia oryzae in wheat by acibenzolar-S-methyl, ethylene and jasmonic acid. Tropical Plant Pathology 39:224–233
Rios VS, Rios JA, Aucique-Pérez CE, Silveira PR, Barros AV, Rodrigues FA (2018) Leaf gas exchange and chlorophyll a fluorescence in soybean leaves infected by Phakopsora pachyrhizi. Journal of Phytopathology 166:75–85
Shaner G, Finney RE (1977) The effect of nitrogen fertilization on the expression of slow-mildewing resistance in Knox wheat. Phytopathology 67:1051–1056
Shine MB, Yang JW, El-Habbak M, Nagyabhyru P, Fu DQ, Navarre D, Ghabrial S, Kachroo P, Kachroo A (2016) Cooperative functioning between phenylalanine ammonia lyase and isochorismate synthase activities contributes to salicylic acid biosynthesis in soybean. New Phytologist 212:627–636
Siah A, Randoux B, Magnin-Robert M, Choma C, Rivière C, Halama P, Reignault P (2018) Natural agents inducing plant resistance against pests and diseases. In: Mérillon JM, Rivière C (eds) Natural antimicrobial agents. Sustainable development and biodiversity series, vol 19. Springer, Cham, pp 121–159
Silva BN, Picanço BBM, Hawerroth C, Silva LC, Rodrigues FA (2022) Physiological and biochemical insights into induced resistance on tomato against septoria leaf spot by a phosphite combined with free amino acids. Physiological and Molecular Plant Pathology 120:101854
Silveira PR, Nascimento KJT, Andrade CCL, Bispo WMS, Oliveira JR, Rodrigues FA (2015) Physiological changes in tomato leaves arising from Xanthomonas gardneri infection. Physiological and Molecular Plant Pathology 92:130–138
Sterling A, Melgarejo LM (2021) Photosynthetic performance of Hevea brasiliensis affected by South American leaf blight under field conditions. European Journal of Plant Pathology 161:953–967
van de Mortel M, Recknor JC, Graham MA, Nettleton D, Dittman JD, Nelson RT, Godoy CV, Abdelnoor RV, Almeida AMR, Baum TJ, Whitham SA (2007) Distinct biphasic mRNA changes in response to Asian soybean rust infection. Molecular Plant-Microbe Interactions 20:887–899
Vlot AC, Sales JH, Lenk M, Bauer K, Brambilla A, Sommer A, Chen Y, Wenig M, Nayem S (2021) Systemic propagation of immunity in plants. New Phytologist 229:1234–1250
Zeier J (2021) Metabolic regulation of systemic acquired resistance. Current Opinion in Plant Biology 62:102050
Acknowledgements
Prof. Rodrigues thanks the National Council for Technological and Scientific Development (CNPq) for his fellowship. This study was financially supported by FertiGlobal (Larderello, Italy), CNPq, and FAPEMIG. This study was financed in part by the Coordenação de Aperfeiçoamento de Pessoal de Nível Superior—Brasil (CAPES)—Finance Code 001.
Author information
Authors and Affiliations
Contributions
Flávia C. T. R. and Fabrício A. R. conceived and designed the experiments. Flávia C. T. R., Marcela U. P. A., Bruno N. S., and Bianca A. F. performed the experiments. Flávia C. T. R. analyzed the data and drafted the manuscript. Fabrício A. R. provided funds for the investigation and revised the drafted manuscript.
Corresponding author
Ethics declarations
Conflict of interest
The authors declare no competing interests.
Additional information
Publisher's note
Springer Nature remains neutral with regard to jurisdictional claims in published maps and institutional affiliations.
Supplementary Information
Below is the link to the electronic supplementary material.
Rights and permissions
Springer Nature or its licensor (e.g. a society or other partner) holds exclusive rights to this article under a publishing agreement with the author(s) or other rightsholder(s); author self-archiving of the accepted manuscript version of this article is solely governed by the terms of such publishing agreement and applicable law.
About this article
Cite this article
Torres Rodrigues, F.C., Araujo, M.U.P., Silva, B.N. et al. A copper-polyphenolic compound as an alternative for the control of Asian soybean rust. Trop. plant pathol. 48, 469–483 (2023). https://doi.org/10.1007/s40858-023-00587-4
Received:
Accepted:
Published:
Issue Date:
DOI: https://doi.org/10.1007/s40858-023-00587-4